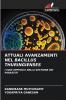
ATTUALI AVANZAMENTI NEL BACILLUS THURINGIENSES

Italian
Paperback
₹5774
₹7606
24.09% OFF
(All inclusive*)
Delivery Options
Please enter pincode to check delivery time.
*COD & Shipping Charges may apply on certain items.
Review final details at checkout.
Looking to place a bulk order? SUBMIT DETAILS
Delivery Options
Please enter pincode to check delivery time.
*COD & Shipping Charges may apply on certain items.
Review final details at checkout.
About The Book
Description
Author(s)
Il Bacillus thuringiensis (B.t.) è un batterio gram-positivo del suolo utilizzato come entomopatogeno per gestire i parassiti dei lepidotteri nei campi e nelle colture orticole. Le varie formulazioni di B.t. sono state utilizzate con successo per proteggere l'ambiente e gli alimenti dalla contaminazione dei residui di pesticidi chimici nella gestione dei parassiti. La scoperta di tossine di B.t. con una nuova attività insetticida contro i parassiti e lo sviluppo di piante geneticamente modificate hanno aperto una nuova era nella gestione dei parassiti. Le colture transgeniche di B.t. tra cui mais cotone e soia sono state prodotte e commercializzate per proteggere le colture da circa 30 parassiti coleotteri e lepidotteri con grande beneficio per l'ambiente e l'economia. Tuttavia con la coltivazione a lungo termine delle colture di B.t. alcuni parassiti bersaglio hanno gradualmente sviluppato una resistenza. Numerosi studi hanno indicato che le mutazioni nei geni per l'attivazione delle tossine per il legame con le tossine e per l'immunizzazione degli insetti sono fonti importanti di resistenza alla B.t.. Un'esplorazione approfondita dei corrispondenti meccanismi di resistenza della t.b. contribuirà alla progettazione di nuove strategie di prevenzione e gestione dei parassiti.
Details
ISBN 13
9786202193337
Publication Date
-13-09-2025
Pages
-96
Weight
-142 grams
Dimensions
-152x229x5.84 mm